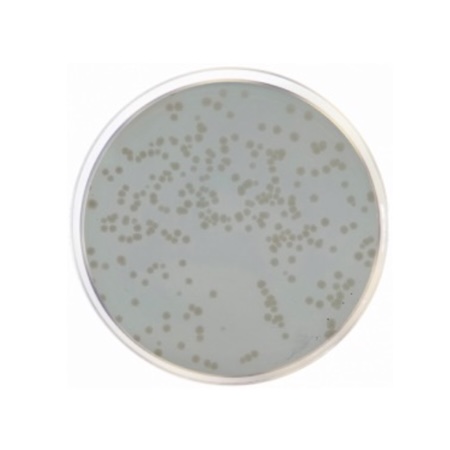

Standard Methods Agar with Powdered Milk (1033) is intended for enumeration of mesophilic microorganisms in milk and dairy products. Its formulation enhances recovery of stressed or damaged cells, providing reliable results in quality control laboratories. The medium is adapted for APHA methods and ISO 4833 standards, ensuring reproducible routine microbiological testing.
Standard Methods Agar with Powdered Milk is a non-selective culture medium developed for enumerating mesophilic bacteria in milk and dairy derivatives. The inclusion of skimmed milk powder improves the recovery of stressed microorganisms commonly found after pasteurization or refrigerated storage. This medium follows the recommendations of APHA and ISO 4833, making it suitable for dairy laboratories, quality control departments, and regulatory compliance testing.
Advantages
- Complies with APHA and ISO 4833 guidelines for dairy microbiology.
- Non-selective formulation supporting a broad range of mesophilic bacteria.
- Enhanced recovery due to skimmed milk powder and casein digest.
- Suitable for plate counts in milk, cream, cheese, butter, and derivative products.
- High transparency and stability for accurate colony enumeration.
Instructions for use
Dissolve the medium in distilled water and heat until complete homogenization. Sterilize by autoclaving at 121 °C for 15 minutes. Cool to 45–50 °C and pour into sterile Petri dishes. Store plates at 2–8 °C and avoid excessive drying. Perform incubations according to APHA or ISO 4833 protocols.
Technical specifications
| Catalogue number | 1033 |
| Product name | Standard Methods Agar with Powdered Milk |
| Brand | Condalab |
| Purpose | Bacterial plate counts in milk and dairy products |
| Compliance | APHA, ISO 4833 |
| Pack size | 500 g |
| Form | Dehydrated culture medium |
Formula (per liter)
| Component | g/L |
|---|---|
| Enzymatic digest of casein | 5 |
| Yeast extract | 2.5 |
| Glucose anhydrous | 1 |
| Skimmed milk powder | 1 |
| Bacteriological agar | 15 |
| Brand | Condalab |